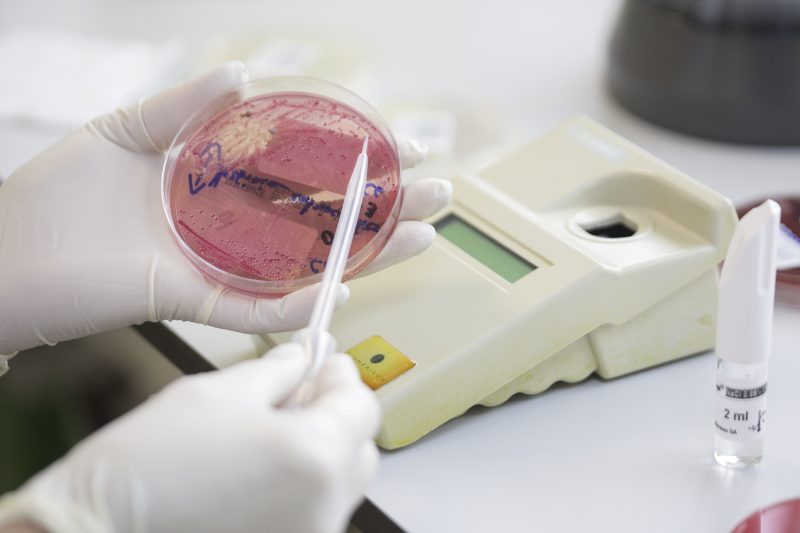

Autoritățile sanitare sucevene sunt în alertă după ce virusul care provoacă holera a fost descoperit pe o plajă din Republica Moldova. Medicii insistă ca oamenii să evite scăldatul în bălţi sau lacuri ale căror ape nu sunt controlate.
Alerta s-a dat în urmă cu două zile după ce autoritățile sanitare din Republica Moldova au anunțat că au descoperit bacteria care provoacă infecția cu holeră pe o plajă de pe malul Nistrului.
Informațiile transmise de autoritățile din Republica Moldova au fost preluate de către responsabilii de la Direcția de Sănătate Publică Suceava.
Aceștia au transmis o atenționare pentru populație, dar și către toate unitățile medicale din județ. Specialiștii recomandă consumarea apei de băut numai din surse controlate, precum și respectarea riguroasă a regulilor de igienă personală și alimentară.
Pentru a depista rapid apariția cazurilor de holeră, DSP Suceava a sporit atenția la triajul epidemiologic în taberele de refugiați și verifică riguros respectarea regulilor igienico-sanitare din aceste tabere.
Holera este o boală infecțioasă bacteriană, care afectează în special intestinul subțire.
Boala se manifestă prin tulburări digestive, vărsături, crampe musculare și deshidratare excesivă.
sursa material: Europa FM